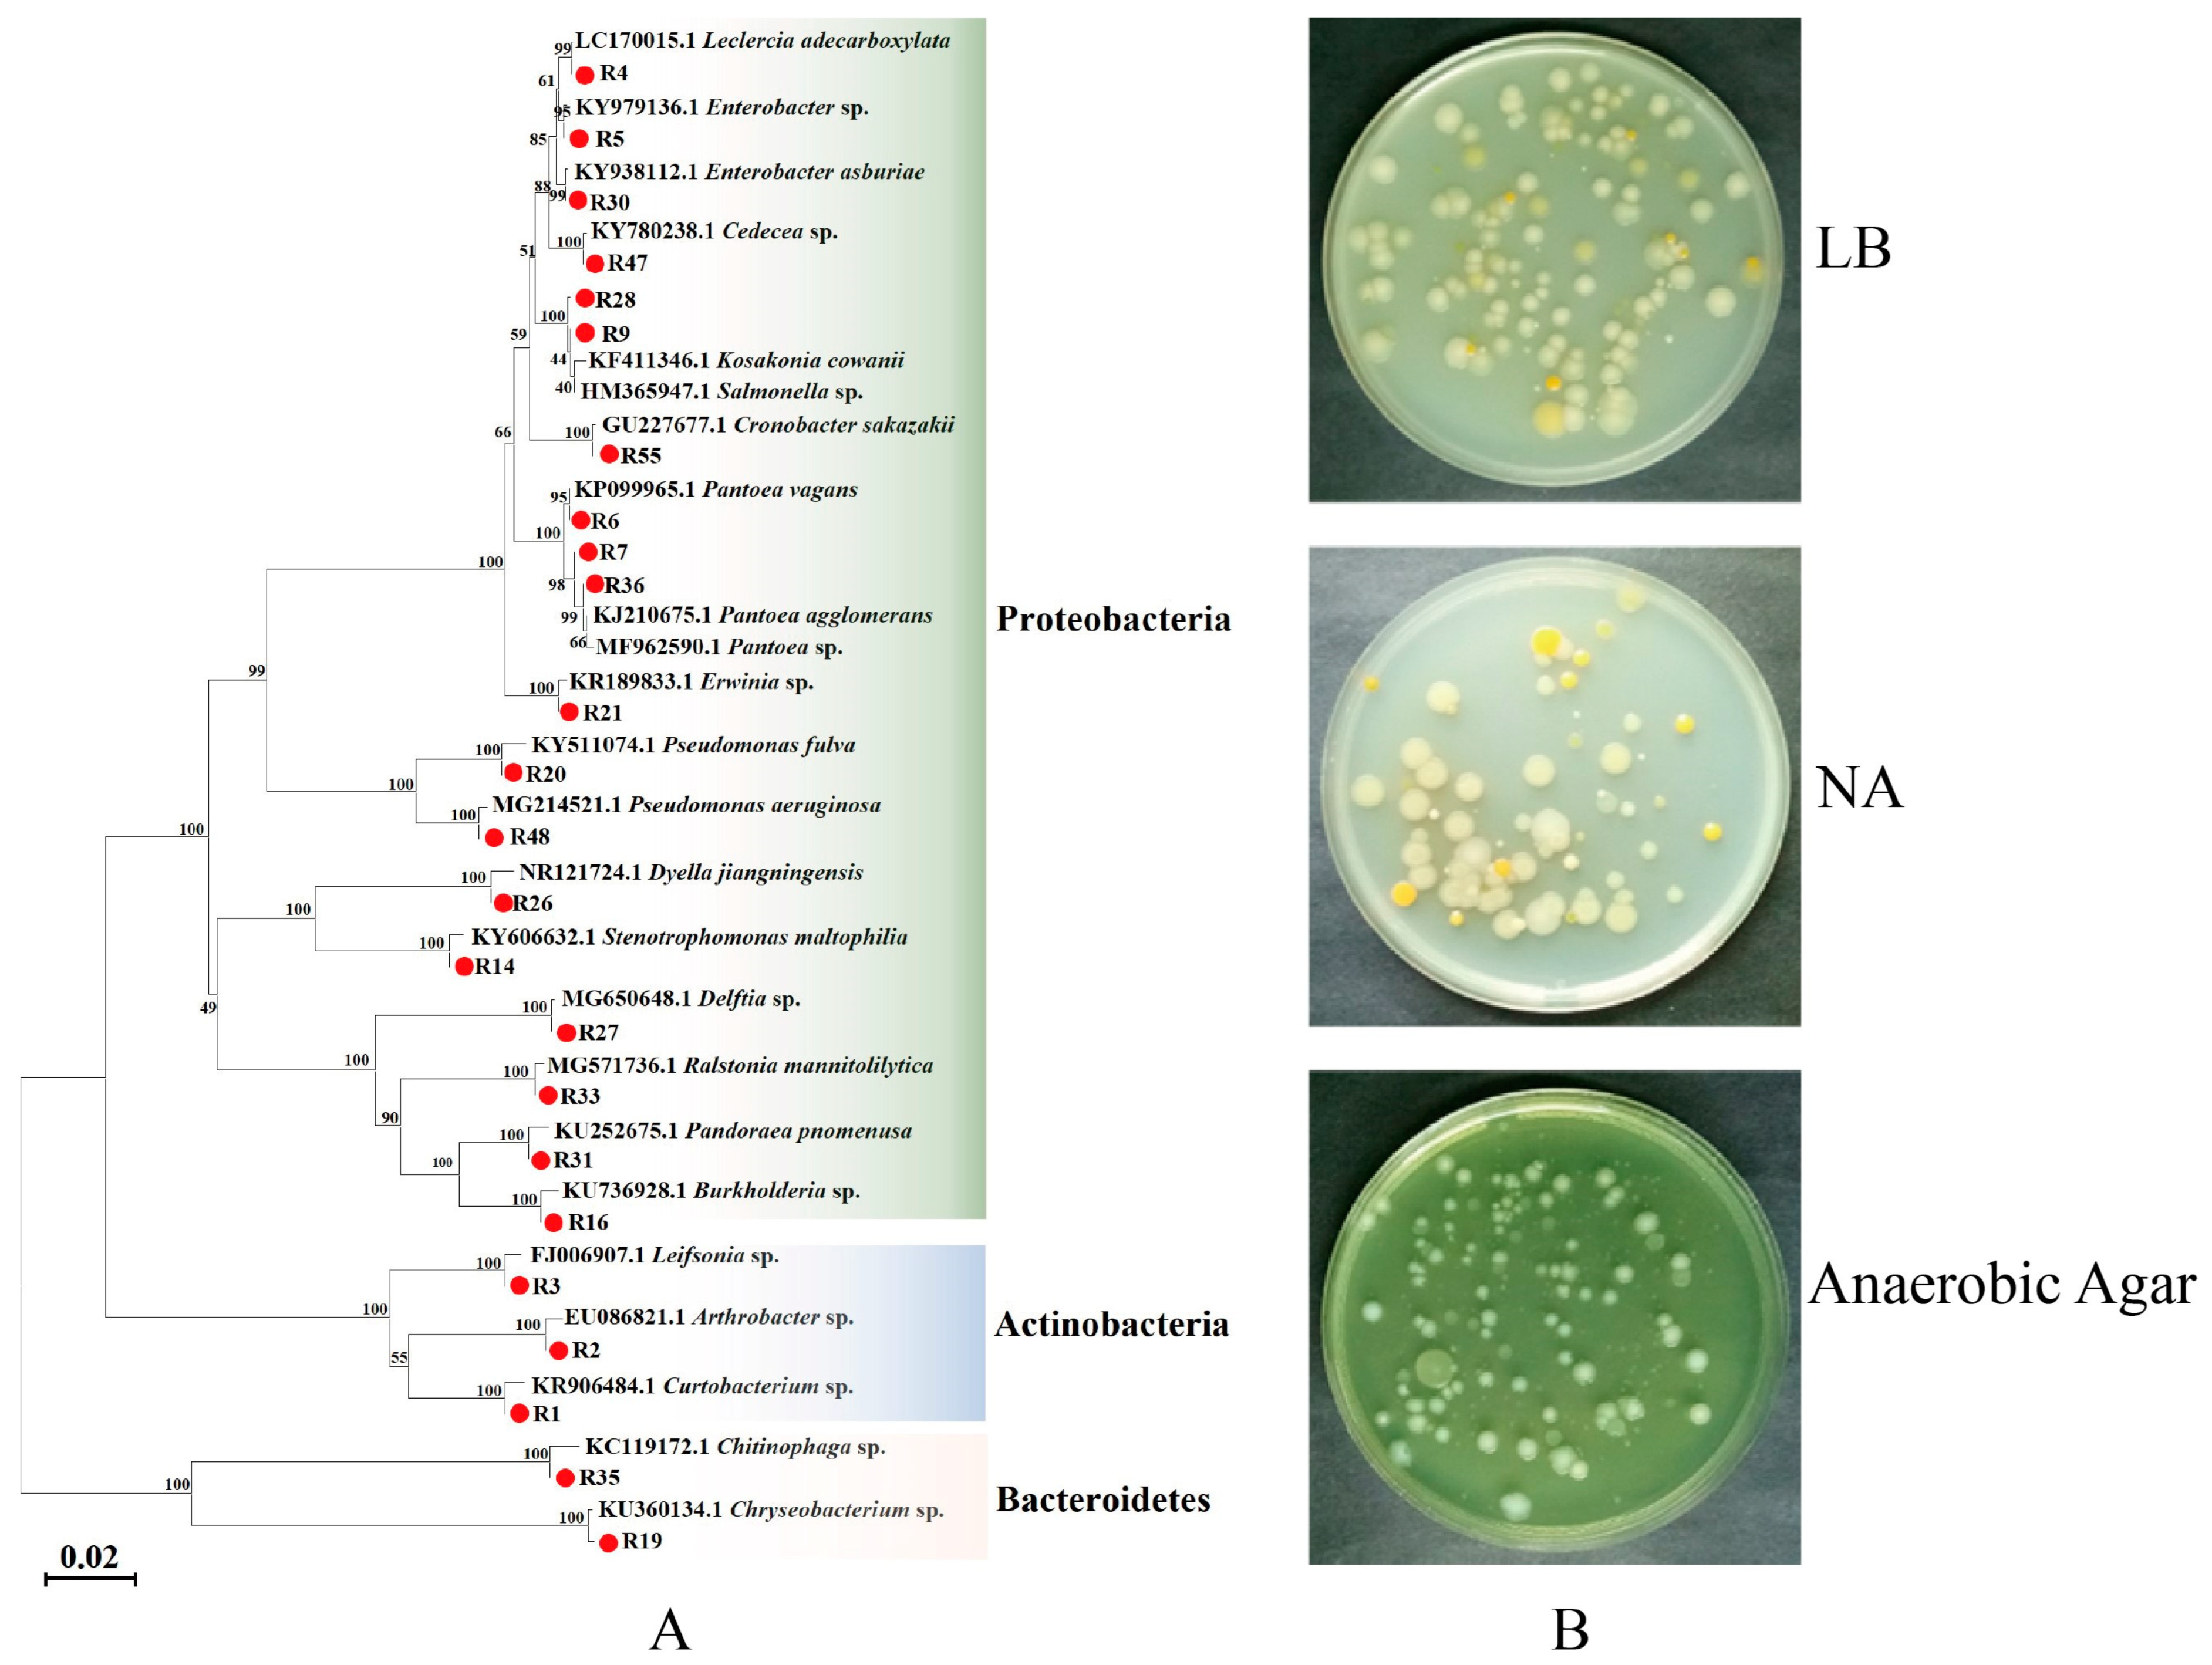
Insects 14 00504 g001 Insects 14 00504 g001

Potential Source and Transmission Pathway of Gut Bacteria in the Diamondback Moth, Plutella xylostella
Abstract
Simple Summary
Abstract
1. Introduction
2. Materials and Methods
2.1. Feeding P. xylostella
2.2. Isolation, Culture, and Identification of Symbiotic Bacteria
2.2.1. Isolation and Culture of Bacteria from Radish Sprouts
2.2.2. Isolation and Culture of Gut Bacteria from P. xylostella
2.2.3. Isolation and Culture of Bacteria from the Ovary of P. xylostella
2.2.4. Isolation and Culture of Bacteria from Eggs of P. xylostella
2.2.5. Identification of Bacteria
2.3. Vertical Transmission of Gut Bacteria of P. xylostella
2.3.1. Tracing Gut Bacterial Transmission by Resistant Bacteria
2.3.2. Detection of Egg Surface Bacteria Entering the Gut
2.4. Horizontal Transmission of Gut Bacteria of P. xylostella
3. Results
3.1. Isolation and Identification of Bacteria from Radish Sprouts
3.2. Isolation and Identification of Gut Bacteria of P. xylostella
3.3. Correlation Analysis between Gut Bacteria of P. xylostella and Food
3.4. Analysis of Vertical Transmission of Gut Bacteria from P. xylostella
3.5. Analysis of Horizontal Transmission of Gut Bacteria from P. xylostella
4. Discussion
5. Conclusions
Supplementary Materials
Author Contributions
Funding
Data Availability Statement
Acknowledgments
Conflicts of Interest
References
- Watanabe, H.; Tokuda, G. Cellulolytic systems in insects. Annu. Rev. Entomol. 2010, 55, 609–632. [Google Scholar] [CrossRef]
- Gao, H.; Bai, L.; Jiang, Y.M.; Huang, W.; Wang, L.L.; Li, S.G.; Zhu, G.D.; Wang, D.Q.; Huang, Z.H.; Li, X.H.; et al. A natural symbiotic bacterium drives mosquito refractoriness to Plasmodium infection via secretion of an antimalarial lipase. Nat. Microbiol. 2021, 6, 806–817. [Google Scholar] [CrossRef]
- Koch, H.; Schmid-Hempel, P. Socially transmitted gut microbiota protect bumble bees against an intestinal parasite. Proc. Natl. Acad. Sci. USA 2011, 108, 19288–19292. [Google Scholar] [CrossRef]
- Dillon, R.J.; Vennard, C.T.; Charnley, A.K. A note: Gut bacteria produce components of a locust cohesion pheromone. J. Appl. Microbiol. 2002, 92, 759. [Google Scholar] [CrossRef]
- Sharon, G.; Segal, D.; Ringo, J.M.; Hefetz, A.; Zilber-Rosenberg, I.; Rosenberg, E. Commensal bacteria play a role in mating preference of Drosophila melanogaster. Proc. Natl. Acad. Sci. USA 2010, 107, 20051. [Google Scholar] [CrossRef] [PubMed]
- Sharon, G.; Segal, D.; Zilberrosenberg, I. Symbiotic bacteria are responsible for diet-induced mating preference in Drosophila melanogaster, providing support for the hologenome concept of evolution. Gut Microbes. 2011, 2, 190–192. [Google Scholar] [CrossRef]
- Meng, L.X.; Xia, C.X.; Jin, Z.X.; Zhang, H.Y. Investigation of gut bacterial communities of asian citrus psyllid (Diaphorina citri) reared on different host plants. Insects 2022, 13, 694. [Google Scholar] [CrossRef] [PubMed]
- Chen, Y.P.; Li, Y.H.; Sun, Z.X.; Du, E.W.; Lu, Z.H.; Li, H.; Gui, F.R. Effects of host plants on bacterial community structure in larvae midgut of Spodoptera frugiperda. Insects 2022, 13, 373. [Google Scholar] [CrossRef] [PubMed]
- Onchuru, T.O.; Martinez, A.J.; Ingham, C.S.; Kaltenpoth, M. Transmission of mutualistic bacteria in social and gregarious insects. Curr. Opin. Insect Sci. 2018, 28, 50–58. [Google Scholar] [CrossRef] [PubMed]
- Koch, H.; Abrol, D.P.; Li, J.; Schmid-Hempel, P. Diversity and evolutionary patterns of bacterial gut associates of corbiculate bees. Mol. Ecol. 2013, 22, 2028–2044. [Google Scholar] [CrossRef] [PubMed]
- Perreau, J.; Patel, D.J.; Anderson, H.; Maeda, G.P.; Elston, K.M.; Barrick, J.E.; Moran, N.A. Vertical Transmission at the Path-ogen-Symbiont Interface: Serratia symbiotica and Aphids. mBio 2021, 12, e00359-21. [Google Scholar] [CrossRef]
- Hongoh, Y.; Deevong, P.; Inoue, T.; Moriya, S.; Trakulnaleamsai, S.; Ohkuma, M.; Vongkaluang, C.; Noparatnaraporn, N.; Kudo, T. Intra- and interspecific comparisons of bacterial diversity and community structure support coevolution of gut microbiota and termite host. Appl. Environ. Microbiol. 2005, 71, 6590–6599. [Google Scholar] [CrossRef] [PubMed]
- Hongoh, Y.; Ekpornprasit, L.; Inoue, T.; Moriya, S.; Trakulnaleamsai, S.; Ohkuma, M.; Noparatnaraporn, N.; Kudo, T. Intra-colony variation of bacterial gut microbiota among castes and ages in the fungus-growing termite macrotermes gilvus. Mol. Ecol. 2006, 15, 505–516. [Google Scholar] [CrossRef]
- Martinson, V.G.; Moy, J.; Moran, N.A. Establishment of characteristic gut bacteria during development of the honeybee worker. Appl. Environ. Micr. 2012, 78, 2830–2840. [Google Scholar] [CrossRef]
- Shaikevich, E.; Romanov, D. Symbiotic Wolbachia bacteria in coccinellid parasitoids: Genetic diversity, horizontal transfer, and recombination. Int. Microbiol. 2022, 26, 269–280. [Google Scholar] [CrossRef] [PubMed]
- Saeed, R.; Ali, H.S.; Sarfraz, A.S.; Syed, M.Z. Effect of different host plants on the fitness of diamondback moth, Plutella xylostella (Lepidoptera: Plutellidae). Crop Prot. 2010, 29, 178–182. [Google Scholar] [CrossRef]
- Furlong, M.J.; Wright, D.J.; Dosdall, L.M. Diamondback moth ecology and management: Problems, progress and prospects. Ann. Rev. Entomol. 2013, 58, 517–541. [Google Scholar] [CrossRef] [PubMed]
- Lin, X.L.; Pan, Q.J.; Tian, H.G.; Douglas, A.E.; Li, T.X. Bacteria abundance and diversity of different life stages of Plutella xylostella (Lepidoptera: Plutellidae), revealed by bacteria culture-dependent and PCR-DGGE methods. Insect Sci. 2015, 22, 375–385. [Google Scholar] [CrossRef]
- Kaur, M.; Thakur, M.; Sagar, V.; Sharma, R. Diversity of culturable gut bacteria of diamondback moth, Plutella xylostella (Lin-naeus) (Lepidoptera: Yponomeutidae) collected from different geographical regions of India. Mol. Biol. Rep. 2022, 49, 7475–7481. [Google Scholar] [CrossRef]
- Li, G.N.; Sun, J.J.; Meng, Y.J.; Yang, C.F.; Chen, Z.; Wu, Y.F.; Tian, L.; Song, F.; Cai, W.Z.; Zhang, X.; et al. The impact of en-vironmental habitats and diets on the gut microbiota diversity of True Bugs (Hemiptera: Heteroptera). Biology 2022, 11, 1039. [Google Scholar] [CrossRef]
- Xia, X.F.; Zheng, D.D.; Zhong, H.Z.; Qin, B.C.; Gurr, G.M.; Vasseur, L.; Lin, H.L.; Bai, J.L.; He, W.Y.; You, M.S. DNA Se-quencing reveals the midgut microbiota of diamondback moth, Plutella xylostella (L.) and a possible relationship with insecticide resistance. PLoS ONE 2013, 8, e68852. [Google Scholar]
- Xia, X.F.; Gurr, G.M.; Vasseur, L.; Zheng, D.D.; Zhong, H.Z.; Qin, B.C.; Lin, J.H.; Wang, Y.; Song, F.Q.; Li, Y.; et al. Metagenomic sequencing of diamondback moth gut microbiome unveils key holobiont adaptations for herbivory. Front. Microbiol. 2017, 8, 663. [Google Scholar] [CrossRef] [PubMed]
- Xia, X.F.; Sun, B.T.; Gurr, G.M.; Vasseur, L.; Xue, M.Q.; You, M.S. Gut microbiota mediate insecticide resistance in the dia-mondback moth, Plutella xylostella (L.). Front. Microbiol. 2018, 9, 25. [Google Scholar] [CrossRef]
- Xia, X.F.; Zheng, D.D.; Lin, H.L.; You, M.S. Isolation and identification of bacteria from the larval midgut of the diamondback moth, Plutella xylostella. Chin. J. Appl. Entomol. 2013, 50, 770–776. [Google Scholar]
- Engel, P.; Martinson, V.G.; Moran, N.A. Functional diversity within the simple gut microbiota of the honey bee. Proc. Natl. Acad. Sci. USA 2012, 109, 11002–11007. [Google Scholar] [CrossRef]
- Yang, Y.J.; Liu, X.G.; Xu, H.X.; Liu, Y.H.; Lu, Z.X. Effects of host plant and insect generation on shaping of the gut microbiota in the Rice Leaffolder, Cnaphalocrocis medinalis. Front. Microbiol. 2022, 13, 824224. [Google Scholar] [CrossRef] [PubMed]
- Wang, A.L.; Yao, Z.C.; Zheng, W.W.; Zhang, H.Y. Bacterial communities in the gut and reproductive organs of Bactrocera minax (Diptera: Tephritidae) based on 454 pyrosequencing. PLoS ONE 2014, 9, e106988. [Google Scholar] [CrossRef]
- Mason, C.J.; Hoover, K.; Felton, G.W. Effects of maize (Zea mays) genotypes and microbial sources in shaping fall armyworm (Spodoptera frugiperda) gut bacterial communities. Sci. Rep. 2021, 11, 4429. [Google Scholar] [CrossRef] [PubMed]
- Akami, M.; Ren, X.M.; Wang, Y.H.; Mansour, A.; Cao, S.; Qi, X.W.; Ngakou, A.; Ngane, R.; Annie, N.; Niu, C.Y. Host fruits shape the changes in the gut microbiota and development of Bactrocera dorsalis (Diptera: Tephritidae) larvae. Int. J. Trop. Insect. Sci. 2022, 42, 2127–2141. [Google Scholar] [CrossRef]
- Medina, V.; Rosso, B.E.; Soria, M.; Gutkind, G.O.; Pagano, E.A.; Zavala, J.A. Feeding on soybean crops changed gut bacteria diversity of the southern green stinkbug (Nezara viridula) and reduced negative effects of some associated bacteria. Pest Manag. Sci. 2022, 78, 4608–4617. [Google Scholar] [CrossRef]
- Voulgari-Kokota, A.; Beukeboom, L.W.; Wertheim, B.; Salles, J.F. Houseflies harbor less diverse microbiota under laboratory conditions but maintain a consistent set of host-associated bacteria. Sci. Rep. 2022, 12, 11132. [Google Scholar] [CrossRef] [PubMed]
- Ma, M.Q.; Chen, X.T.; Li, S.Q.; Luo, J.; Han, R.H.; Xu, L. Composition and diversity of gut bacterial community in different life stages of a leaf beetle Gastrolina Depressa. Microb. Ecol. 2022. [Google Scholar] [CrossRef]
- Wu, X.L.; Xia, X.F.; Chen, J.H.; Geoff, M.G.; You, M.S. Effects of different foods on intestinal bacterial diversity of diamondback moth larvae. Acta Entomol. Sin. 2019, 62, 1172–1185. [Google Scholar]
- Meng, Y.J.; Li, S.; Zhang, C.; Zheng, H. Strain-level profiling with picodroplet microfluidic cultivation reveals host-specific adaption of honeybee gut symbionts. Microbiome 2022, 10, 140. [Google Scholar] [CrossRef] [PubMed]
- Knorr, E.; Schmidtberg, H.; Arslan, D.; Bingsohn, L.; Vilcinskas, A. Translocation of bacteria from the gut to the eggs triggers maternal transgenerational immune priming in Tribolium castaneum. Biol. Lett. 2015, 11, 20150885. [Google Scholar] [CrossRef]
- Holley, J.C.; Jackson, M.N.; Pham, A.T.; Hatcher, S.C.; Moran, N.A. Carpenter bees (Xylocopa) harbor a distinctive gut microbiome related to that of honey bees and bumble bees. Appl. Environ. Microb. 2022, 88, e0020322. [Google Scholar] [CrossRef]

| Strain | Sequence Alignment | Sources | |||
|---|---|---|---|---|---|
| Sequence A | Sequence B | Identity | B | A | |
| Enterobacter sp. | R5 | R30 | 99% | Radish sprouts | Radish sprouts |
| RL1 | 99% | Larval gut | |||
| RP1-2, RP3-8 | 99% | Pupal gut | |||
| RM-1 | 99% | Adult gut | |||
| OV4, OV9, OV21, OV32 | 99% | Ovary | |||
| OV16 | 98% | Ovary | |||
| RE1, RE7, RE41 | 99% | Egg | |||
| Pantoea sp. | R6 | R7, R36 | 99% | Radish sprouts | Radish sprouts |
| RL5, RL15 | 99% | Larval gut | |||
| RL19 | 98% | Larval gut | |||
| OV1 | 99% | Ovary | |||
| Cedecea sp. | R47 | RL3 | 100% | Larval gut | Radish sprouts |
| OV24 | 100% | Ovary | |||
| Pseudomonas sp. | R20 | R48 | 95% | Radish sprouts | Radish sprouts |
| RM-43 | 99% | Adult gut | |||
| RE26 | 100% | Egg | |||
| Brachybacterium sp. | RP3-4 | RM-41 | 97% | Adult gut | Pupal gut |
| Enterococcus sp. | RP1-5 | OV25 | 97% | Ovary | Pupal gut |
| Carnobacterium sp. | OV2 | OV7 | 99% | Ovary | Ovary |
| Lysinibacillus sp. | OV28 | SE1 | 99% | Egg | Ovary |
Disclaimer/Publisher’s Note: The statements, opinions and data contained in all publications are solely those of the individual author(s) and contributor(s) and not of MDPI and/or the editor(s). MDPI and/or the editor(s) disclaim responsibility for any injury to people or property resulting from any ideas, methods, instructions or products referred to in the content. |
© 2023 by the authors. Licensee MDPI, Basel, Switzerland. This article is an open access article distributed under the terms and conditions of the Creative Commons Attribution (CC BY) license (https://creativecommons.org/licenses/by/4.0/).
Share and Cite
Han, S.; Ai, Q.; Xia, X. Potential Source and Transmission Pathway of Gut Bacteria in the Diamondback Moth, Plutella xylostella. Insects 2023, 14, 504. https://doi.org/10.3390/insects14060504
Han S, Ai Q, Xia X. Potential Source and Transmission Pathway of Gut Bacteria in the Diamondback Moth, Plutella xylostella. Insects. 2023; 14(6):504. https://doi.org/10.3390/insects14060504
Chicago/Turabian StyleHan, Shuncai, Qianqian Ai, and Xiaofeng Xia. 2023. "Potential Source and Transmission Pathway of Gut Bacteria in the Diamondback Moth, Plutella xylostella" Insects 14, no. 6: 504. https://doi.org/10.3390/insects14060504
APA StyleHan, S., Ai, Q., & Xia, X. (2023). Potential Source and Transmission Pathway of Gut Bacteria in the Diamondback Moth, Plutella xylostella. Insects, 14(6), 504. https://doi.org/10.3390/insects14060504
